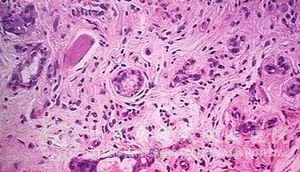

北京京城皮肤医院提供网络预约挂号服务
预约挂号热线:010-64888999
三级专科
医保定点
舒适环境
无假日
京城皮肤医院的皮肤介绍,汗管瘤作为一种良性肿瘤,它的临床上的组织病理表现为以下几个方面:
1. 形状为圆形,椭圆形或者蝌蚪状;
2. 通过病理检查可在 浅层上发现双层嗜碱性上皮*形成囊腔样结构;
3. 上皮*出现嗜伊红胶样物;
相关阅读: